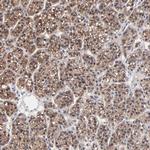
PPFIBP2 Antibody in Immunohistochemistry (Paraffin) (IHC (P))

Search
Invitrogen
PPFIBP2 Polyclonal Antibody
{{$productOrderCtrl.translations['antibody.pdp.commerceCard.promotion.promotions']}}
{{$productOrderCtrl.translations['antibody.pdp.commerceCard.promotion.viewpromo']}}
{{$productOrderCtrl.translations['antibody.pdp.commerceCard.promotion.promocode']}}: {{promo.promoCode}} {{promo.promoTitle}} {{promo.promoDescription}}. {{$productOrderCtrl.translations['antibody.pdp.commerceCard.promotion.learnmore']}}

Please note: We are reviewing Western blot images included in the antibody testing data in our catalog, including those provided by third parties. Unless expressly labeled or annotated as “raw-unedited”, Western blot images included in the antibody testing data in our catalog may have been edited, optimized or otherwise adjusted for presentation.
产品信息
PA5-51666
种属反应
宿主/亚型
分类
类型
抗原
偶联物
形式
浓度
规格
纯化类型
保存液
内含物
保存条件
运输条件
RRID
产品详细信息
Immunogen sequence: SGATPNGEAA KSPPTICQPD ATGSSLLRLR DTESGWDDTA VVNDLSSTSS GTESGPQSPL TPDGKRNPKG IKKFWGKIRR TQSGNFYTDT LGMAEFRRGG L
Highest antigen sequence identity to the following orthologs: Mouse - 76%, Rat - 80%.
靶标信息
The PPFIBP2 (PPFIA Binding Protein 2) gene encodes a protein that belongs to the liprin family, which is involved in intracellular signaling and cytoskeletal organization. Located on chromosome 1, PPFIBP2 is primarily known for its role in synaptic function and cell adhesion. The protein interacts with receptor protein tyrosine phosphatases, particularly PTPRF and PTPRD, and plays a critical role in the formation and maintenance of synaptic contacts. PPFIBP2 facilitates the proper localization of synaptic vesicles and synapse-specific proteins, contributing to synaptic stability and plasticity. Disruption of PPFIBP2 expression or function has been linked to neurological disorders, emphasizing its importance in neural communication. Additionally, PPFIBP2 has been implicated in cancer, where it may influence tumor cell adhesion and migration.
仅用于科研。不用于诊断过程。未经明确授权不得转售。
篇参考文献 (0)
生物信息学
蛋白别名: Liprin-beta-2; Protein tyrosine phosphatase receptor type f polypeptide-interacting protein-binding protein 2; PTPRF-interacting protein-binding protein 2
基因别名: PPFIBP2
Entrez Gene ID: (Human) 8495




